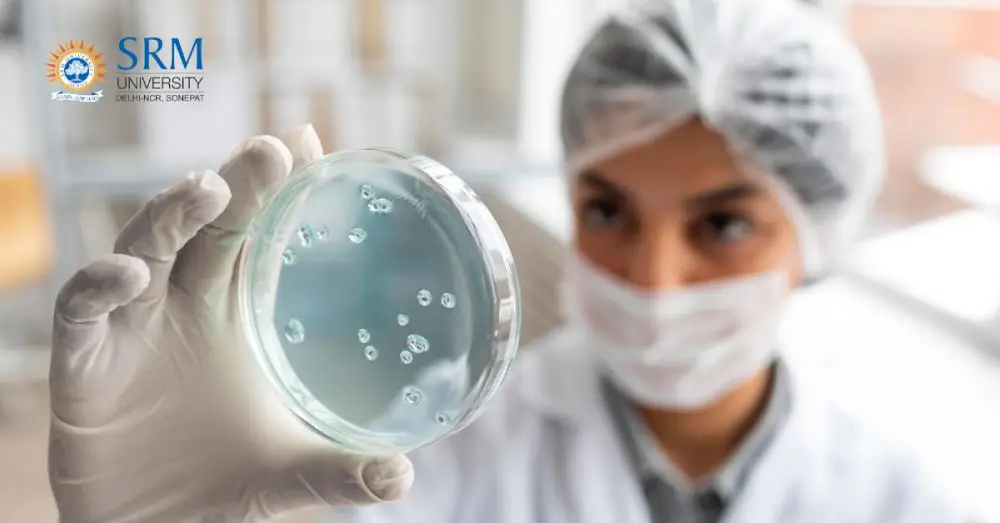

The top court was hearing a plea filed by a co-owner of the residential property having 42 rooms in Bengaluru. The petitioner along with other co-owners executed a lease deed in favour of the lessee, namely M/s D Twelve Spaces …
AIDSO and educationists warn this could severely affect students from economically disadvantaged backgrounds. The All India Democratic Students’ Organisation (AIDSO) has written to the Department of Collegiate Education opposing plans by Dr Manmohan Singh Bangalore City University (BCU) to convert …
Picture this: you are in the school’s biology lab, looking at the microscope. What you see is not just about the shapes—it is an invisible world forming with bacteria, viruses, and fungi. For some, it is just a chapter in …
2.1 Introduction CCLP Worldwide International School Rankings 2025–26 – India (International Category) CCLP Worldwide – Education Charter International, in association with the UNESCO Club of Education Charter and partner educational organisations, is conducting an independent, research-based study to identify and …
Key points: As someone who’s dedicated my career to advancing the Science of Reading movement, I’ve seen firsthand what it takes to help every child become a strong, fluent reader. We’ve made incredible strides in shifting the conversation toward evidence-based …
US visa uncertainty has now broken the old model, along with Asia’s compensation and opportunities catching up, and companies changing their global hiring strategy, Singh added. “Now it’s ‘Build teams where talent already is’.” New Delhi | Bengaluru: IIT placements …
It is surprising to note that the documents they provided at the time of admission included a Transfer Certificate from their old school, which was a copy of the original TC they had already used for initial admission to the …
The event was coordinated by Dr Anita Shukla, coordinator of the Education, Mobility and Employability Training Programme, in association with Help the Blind Foundation Vadodara: The equal opportunity cell (EOC) of Maharaja Sayajirao University (MSU) on Tuesday organized a special …
Redefining Our Careers: Two Women’s Leap into Technology By Danielle Imoesiri, Lisette Buckman 12/04/25 According to a Deloitte report, 53% of IT professionals now come from outside the traditional tech sector, transitioning from industries such as professional services, …
Traditionally, colleges under Mangalore University have observed Christmas holidays. Last year, too, MU scheduled examinations during the Christmas and New Year break, but rescheduled only after colleges expressed opposition Mangaluru: Students, parents, and college managements have urged Mangalore University (MU) …